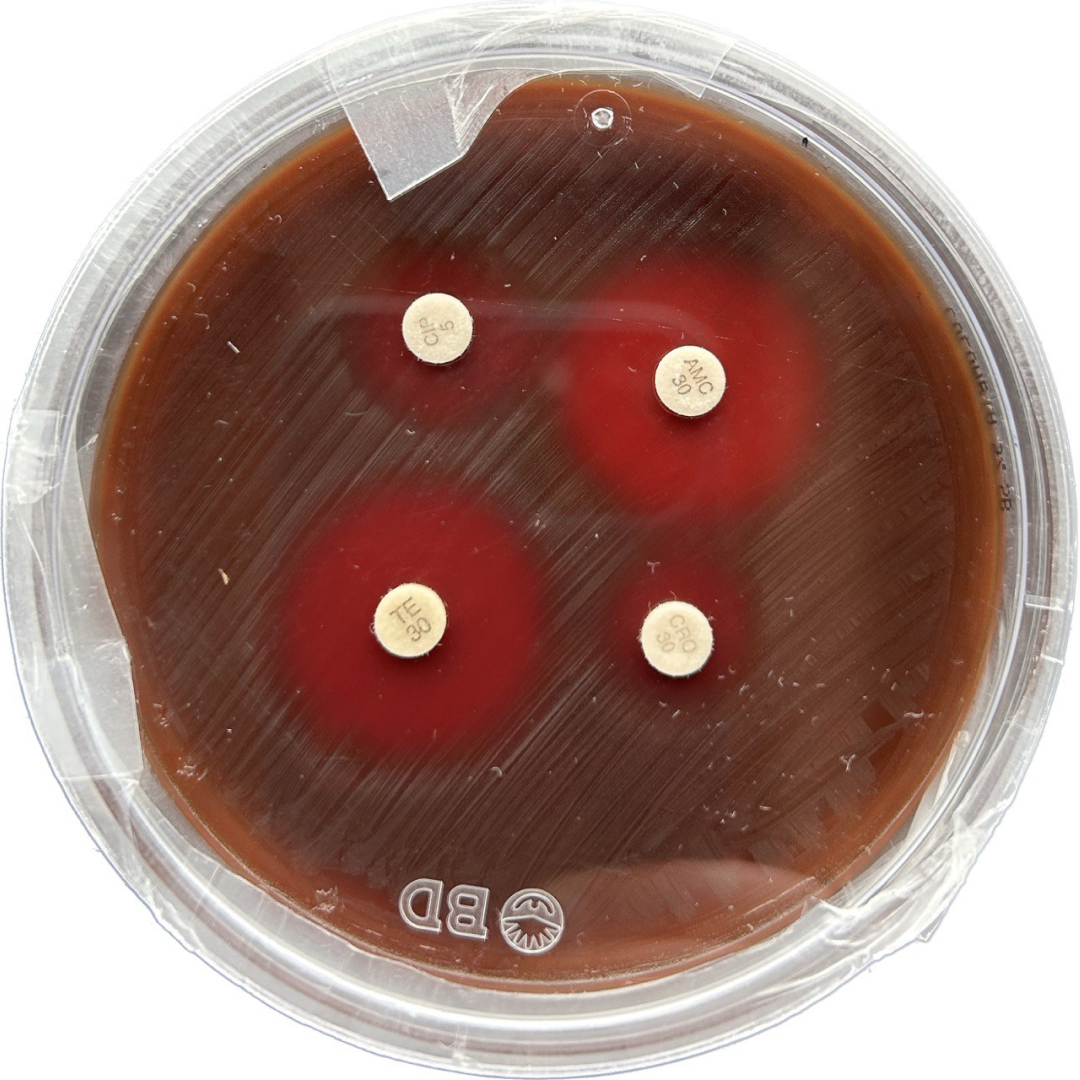
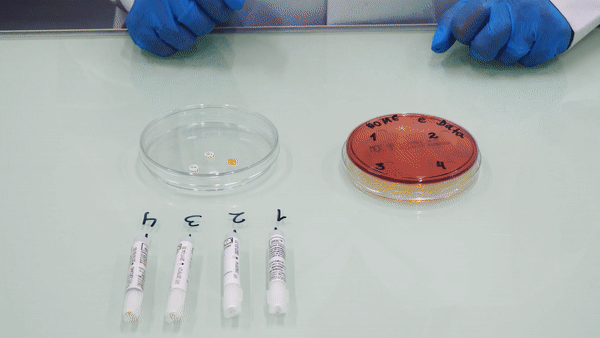

This workshop provides a hands-on experience to explore antimicrobial resistance through practical
microbiology activities designed for easy replication in diverse settings. Through interactive,
hands-on activities in a real microbiology laboratory, this workshop immerses participants in the
science of antimicrobial resistance by answering fundamental questions such as: What are
antibiotics? How do they work? What does antimicrobial resistance mean? The activity refers to the
concept of the antibiogram, which is the action performed by scientists in the laboratory to test
the efficacy of antibiotics on specific bacteria. In order to do so, antibiotic pills are placed
into a transparent lidded dish (called Petri dish) covered with bacteria. After some cultivation
hours, it is possible to observe the efficacy of antibiotics that prevent bacteria from growing. The
higher the antibiotic efficacy, the less the bacteria spread, leaving an empty space around the
pill. On the other hand, the smaller the area, the higher the resistance development of microbes
which are not affected by the antibiotic.
Participants begin with an introduction to antimicrobial resistance and the importance of responsible
antibiotic use. They then move to a microbiology laboratory, where safety procedures are explained,
and they learn about antibiotics and bacterial differences through microscope observations.
Following step-by-step instructions, participants culture bacteria, Escherichia coli first, on Petri
dishes and place antibiotic pills based on their personal responses to questions about antibiotic
use and health habits. After incubation, the clear zones around the antibiotics where bacteria do
not grow reveal the effectiveness of each drug and highlight the link between individual behaviour
and resistance development. The workshop combines rigorous scientific content with interactive and
creative engagement to empower participants in the fight against antibiotic misuse. Because the
activities involve live microorganisms and antibiotics, they are conducted in microbiology
laboratories and facilitated by microbiology experts who co-designed the format.